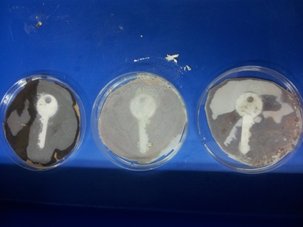
שלושה מפתחות בתמיסות כימיות

TEMI activities developed in Israel
The mystery of the disappearing laboratory report
 Abstract: Students painstakingly prepared a laboratory report. For some reason the written results suddenly vanished. Now, the students need to find out why the writing vanished and how to recover the data that disappeared
Abstract: Students painstakingly prepared a laboratory report. For some reason the written results suddenly vanished. Now, the students need to find out why the writing vanished and how to recover the data that disappeared
Topics: Energy, chemical equilibrium, thermodynamics
Downloads:
![]() For students – (Word)
For students – (Word)
For students – (PDF)
![]() For teacher – (Word)
For teacher – (Word)
The clock reaction
 Abstract: Two translucent liquids are mixed. At first nothing happens, the resulting solution is still translucent. Suddenly with no warning the solution turns blue-black all at once.
Abstract: Two translucent liquids are mixed. At first nothing happens, the resulting solution is still translucent. Suddenly with no warning the solution turns blue-black all at once.
Topics: Redox reactions, rate of reaction (kinetics)
Downloads:
For students – (PDF)
![]() For teacher – (Word)
For teacher – (Word)
The sea-sand overseas
 Abstract: 'Dry' sand is mysterious sand that stays dry when water is poured onto it. Students are requested to find ways to build sand castles with this 'dry' sand.
Abstract: 'Dry' sand is mysterious sand that stays dry when water is poured onto it. Students are requested to find ways to build sand castles with this 'dry' sand.
Topics: Chemical Bonding; hydrophobic and hydrophilic properties
Downloads:
![]() For students – (Word)
For students – (Word)
For students – (PDF)
![]() For teacher – (Word)
For teacher – (Word)
Love meter
 Abstract: The 'love meter' is a device which according to folklore determines whether someone is in love. Students investigate what the link is between love, temperature, vapour pressure and gas laws.
Abstract: The 'love meter' is a device which according to folklore determines whether someone is in love. Students investigate what the link is between love, temperature, vapour pressure and gas laws.
Topics: The ideal gas law, pressure, volume, temperature, Vapour pressure of volatile liquids.
Downloads:
![]() love_student – (Word)
love_student – (Word)
For students – (PDF)
![]() For teacher – (Word)
For teacher – (Word)
The tell-tale key
Abstract: The school lab was broken into. At first it seems the culprit will never be found. But the lab technician takes one look at the floor and knows exactly who it was. Why did the culprits key leave a footprint? The activity was developed by Ben Osher who participated in one of Weizmann's TEMI cohorts.
Abstract: The school lab was broken into. At first it seems the culprit will never be found. But the lab technician takes one look at the floor and knows exactly who it was. Why did the culprits key leave a footprint? The activity was developed by Ben Osher who participated in one of Weizmann's TEMI cohorts.
Topics: Ionic materials, dissolution reactions and precipitation reactions
Downloads:
![]() For students – (Word)
For students – (Word)
For students – (PDF)
A Volcano is born
 Abstract: The earth beneath us seems stable. That is most of the time. But every once in a while it opens up and lava gushes out from the new crevice. This experiment emulates the birth of a volcano. The activity was developed by Hanin Bishara and Rawda Ghanem who participated in one of Weizmann's TEMI cohorts
Abstract: The earth beneath us seems stable. That is most of the time. But every once in a while it opens up and lava gushes out from the new crevice. This experiment emulates the birth of a volcano. The activity was developed by Hanin Bishara and Rawda Ghanem who participated in one of Weizmann's TEMI cohorts
Topics: States of matter, phase transition, density
Downloads:
![]() For students – (Word)
For students – (Word)
For students – (PDF)
The Chinese teapot
 Abstract: An old teapot is passed from generation to generation. Supposedly it has magic powers. One day while serving tea to guests, these powers are revealed. It turns out the tea changes colour with each pouring.
Abstract: An old teapot is passed from generation to generation. Supposedly it has magic powers. One day while serving tea to guests, these powers are revealed. It turns out the tea changes colour with each pouring.
Topics: Acids and bases, indicators
Downloads:
![]() For students – (Word)
For students – (Word)
For students – (PDF)
Israeli versions of TEMI activities developed by other partners
The Israeli chemical garden
 Abstract: The "Chemical garden" experiment is based on Salts are added to a clear solution. Within minutes or hours colourful structures are formed. The story has an Israeli aspect to it, as the first Israeli astronaut conducted this experiment in space. Sadly, the space shuttle he was in crashed on the way back to earth. Originally developed by University of Bremen, the Israeli TEMI team adapted it.
Abstract: The "Chemical garden" experiment is based on Salts are added to a clear solution. Within minutes or hours colourful structures are formed. The story has an Israeli aspect to it, as the first Israeli astronaut conducted this experiment in space. Sadly, the space shuttle he was in crashed on the way back to earth. Originally developed by University of Bremen, the Israeli TEMI team adapted it.
Topics: Salts, solubility, diffusion, precipitation, solubility
Downloads:
Coming soon
How to make silver and gold from copper
 Abstract: An old recipe for turning copper to gold is found. It was written by an alchemist many centuries ago. Will it work? A copper coin is placed in a boiling solution, it quickly turns silver. Upon heating it on a hot plate it turns gold in colour. The activity was originally developed by Charles University, Prague and then adapted by Smadar Aharoni-Gerbat, Sara Aker, Batia Lifshitz-Goldreich, Sharon Deutsch & Pnina Yakirevich who participated in one of Weizmann's TEMI cohorts
Abstract: An old recipe for turning copper to gold is found. It was written by an alchemist many centuries ago. Will it work? A copper coin is placed in a boiling solution, it quickly turns silver. Upon heating it on a hot plate it turns gold in colour. The activity was originally developed by Charles University, Prague and then adapted by Smadar Aharoni-Gerbat, Sara Aker, Batia Lifshitz-Goldreich, Sharon Deutsch & Pnina Yakirevich who participated in one of Weizmann's TEMI cohorts
Topics: Redox reactions
Downloads:
![]() For students – (Word)
For students – (Word)
For students – (PDF)
The Israeli Genie
 Abstract: An old bottle is found. It is an heirloom that has been in the family for centuries. Once the cork is opened a Genie residing in the bottle escapes it. Is the Genie real? Where did it come from? Are there other such 'Genies' in the real world? The activity was originally developed by University of Vienna, the Israeli TEMI team adapted it.
Abstract: An old bottle is found. It is an heirloom that has been in the family for centuries. Once the cork is opened a Genie residing in the bottle escapes it. Is the Genie real? Where did it come from? Are there other such 'Genies' in the real world? The activity was originally developed by University of Vienna, the Israeli TEMI team adapted it.
Topics: Exothermic reactions, states of matter
Downloads:
![]() A Presentation – (Powerpoint)
A Presentation – (Powerpoint)

